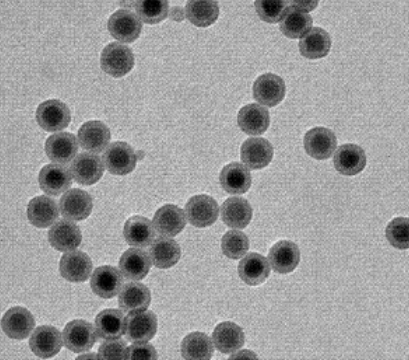
上转换纳米颗粒

油溶性上转换纳米颗粒(980激发)的应用以及相关产品
油无水磷酸氢上换算纳米技术粒子(980刺激)Oil soluble Upconverting Nanoparticle,应用近红外连着激光机器用于刺激源的上切换nm塑料颗粒束兼备较深的光刺穿角度,无情况荧光骚扰,对生物工程机构可以说不能问题,油阴离子型的上切换nm塑料颗粒束兼备非常好的固定性分析,也可以于载药激光散斑装置的学习。

pg电子娱乐游戏app
微信公众号
官方微信